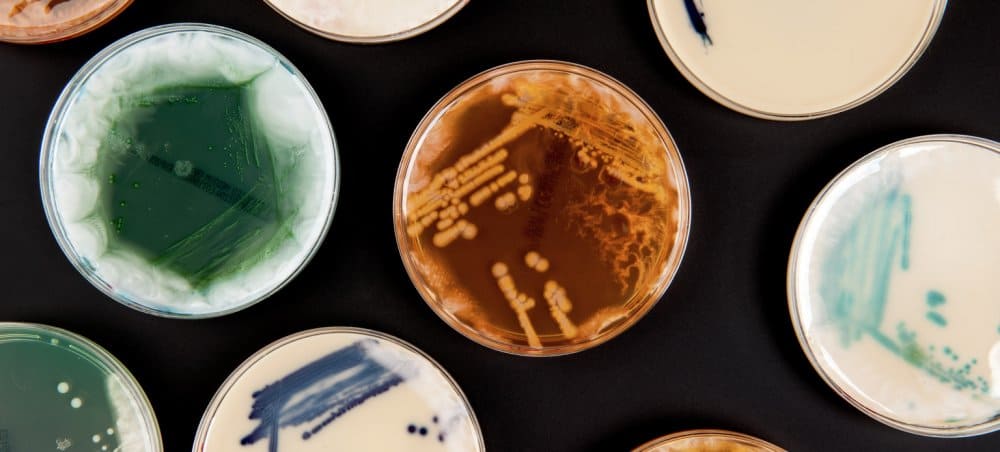

Researcher awarded €1.5 million to create new antibiotics that can kill drug resistant superbugs. A Queen’s University Belfast researcher has been awarded €1.5 million for a mission to help develop new types of antibiotics that can target and kill bacteria that are resistant to current antibiotics. Antimicrobial resistance is a major global health threat, accounting […]
Read More… from Grant to create new antibiotics for superbugs